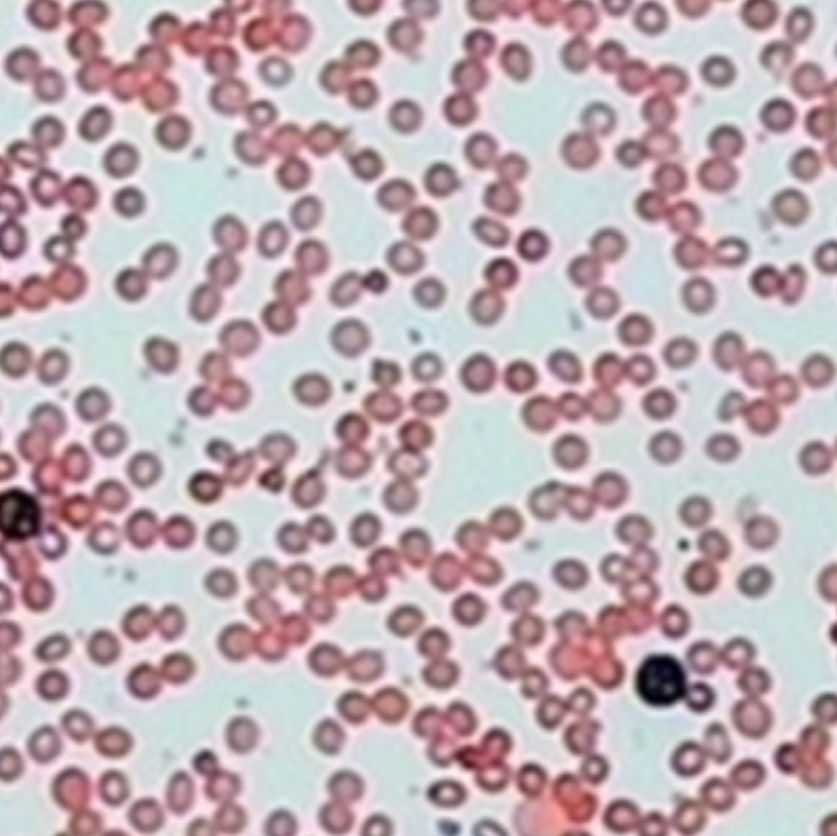
碱性磷酸酶染色服务

- 详细信息
- 文献和实验
- 技术资料
碱性磷酸酶染色(NAP)碱性磷酸酶染色( NAP)在临床的应用基本属于常规筛查的染色法;专门用于血液或骨髓细胞涂片的中性粒细胞的碱性磷酸酶染色,又称同时偶联法。碱性磷酸酶活性部位呈蓝色,位于胞浆中。油镜下计数101个中性粒细胞,求出百分比和积分。非特异性反应少,结果可靠。
风险提示:丁香通仅作为第三方平台,为商家信息发布提供平台空间。用户咨询产品时请注意保护个人信息及财产安全,合理判断,谨慎选购商品,商家和用户对交易行为负责。对于医疗器械类产品,请先查证核实企业经营资质和医疗器械产品注册证情况。
文献和实验碱性磷酸酶染色(NAP)
碱性磷酸酶染色( NAP)在临床的应用基本属于常规筛查的染色法。专门用于血液或骨髓细胞涂片的中性粒细胞的碱性磷酸酶染色,又称同时偶联法。碱性磷酸酶活性部位呈蓝色,位于胞浆中。油镜下计数101个中性粒细胞,求出百分比和积分。非特异性反应少,结果可靠。
碱性磷酸酶染色原理(偶氮偶联法):血细胞内的碱性磷酸酶在pH 9.4-9.6的条件下将基质液中的α-磷酸萘酚钠
水解,产生α-萘酚与重氨盐偶联形成不溶性灰黑色沉淀,定位于酶活性所在之处。
结果判断:阳性结果为胞质内出现灰褐色至深黑色颗粒状或片状沉淀
①(-)灰褐色沉淀,为0分。
②(+)胞质出现灰褐色沉淀,为1分。
③(++)胞质深褐色沉淀,为2分。
④(+++)胞质中已基本充满棕黑色颗粒状沉淀,但密度较低,为3分。
⑤(++++)胞质全被深黑色团块沉淀所充满,密度高,甚至遮盖胞核为4分。
切片3张以上免制备费 染色服务 类别 服务项目 备注 说明 染色 HE染色 染色 苏木精-伊红染色法,观察组织形态 冰冻HE染色 染色 苏木精-伊红染色法,观察组织形态 油红O染色 染色 4%多聚甲醛固定,冰冻切片。对组织内脂质(如脂滴)染色 番红固绿染色 染色 常用于植物、软骨
一、实验目的 1.掌握酶分离纯化的一般步骤及相关原理; 2.悉碱性磷酸酶的分离纯化的方法步骤。 二、实验原理 有机溶剂分级沉淀是分离蛋白质的常用方法之一。有机溶剂能使许多溶于水的酌生物大分子发生沉淀,其主要作用是降低水溶液的介电常数。例如20℃时水的介电常数为80,82%的乙醇溶液的介电常数为40。溶液的介电常数降低意味着溶质分子间异性电荷库仑引力增加,从而使溶质的溶解度降低
高。如果有相同的抗原决定簇时,则会有交叉反应。方法成熟,使用广泛的还是经典的组织化学方法。下面以碱性磷酸酶的显示方法来学习经典酶组织化学的理论及操作。经典酶组织化学不是显示酶本身,常采用的方法是:在一定条件下,使细胞中的酶作用于酶的底物,使其产物在原地进行捕捉、沉淀转化为有色产物。碱性磷酸酶(AKP)的显示方法最早由Gomeri(1939)提出,现在这种方法称为Gomeri法。碱性磷酸酶是指磷酸单酯酶Ⅰ,它能在pH8.6~10.0的最适条件下分解磷酸单酯,对于与磷酸相接的醇基没有特异性,Gomeri法
技术资料暂无技术资料 索取技术资料